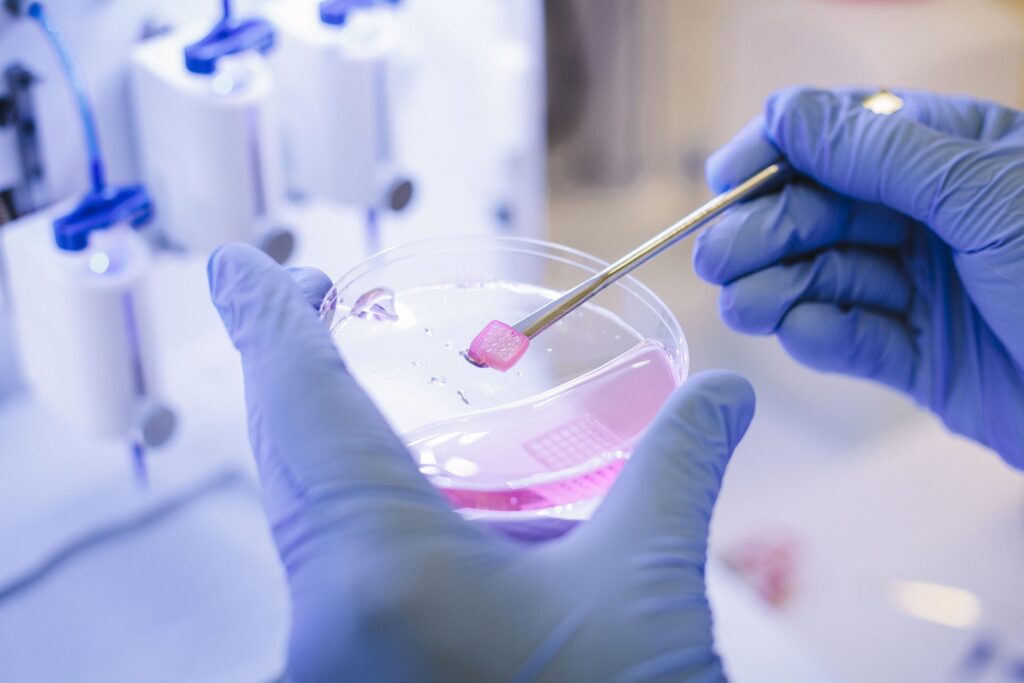
Biomaterial Industry

In the china biomaterial industry stands as a beacon of this transformation, projecting an impressive Compound Annual Growth Rate (CAGR) of 13.4% from 2023 to 2033. This market encompasses a wide array of materials—ranging from polymers, ceramics, metals to composite substances—deployed in a spectrum of devices spanning orthopedic implants, drug delivery systems, and advanced wound care solutions.
China’s dynamic market landscape is witnessing a seismic shift, particularly in the realm of biomaterials. With industries like tissue engineering, pharmaceuticals, and healthcare at the forefront, biomaterials—vital elements interacting with biological systems—are steering a remarkable market expansion. The nation’s aging population, escalating healthcare expenditures, and remarkable strides in biomaterial technology serve as catalysts propelling this unprecedented growth.
Request to Sample of this Report: https://www.futuremarketinsights.com/reports/sample/rep-gb-15168The burgeoning opportunities within China’s expanding biomaterials sector extend to both domestic enterprises and global entities eager to tap into this burgeoning market. As biomaterials increasingly integrate with various industries, the potential for innovation and collaboration is unprecedented.
The confluence of evolving demographics, escalating healthcare needs, and groundbreaking advancements in biomaterial technology within China signifies an unparalleled opportunity for industry stakeholders. Whether domestic or international, businesses are poised to leverage this thriving market, fostering groundbreaking solutions and driving transformative growth.
The prevalence of musculoskeletal and chronic skeletal diseases is likely to increase demand for medical implants, fueling market expansion. A growing elderly population puts them at a higher risk of developing osteoarthritis, osteoporosis, and other musculoskeletal conditions. In turn surging for smart orthopedic implants market demand.
Bridging the Gap Between Science and Healthcare Needs with Biomaterials:
The biomaterials and tissue engineering market is expanding due to the aging population, increased incidence of cardiovascular and orthopedic issues, technical medical developments, and rising public awareness of implantable devices. Increasing consumer awareness of the advantages of products based on biomaterials and increased government funding for biomaterials research and development are contributing to the market expansion.
Compatibility issues and expensive implants are expected to restrict global Biomaterial Market growth. On the other hand, new product introductions in plastic surgery, wound healing, and neurology are anticipated to present lucrative opportunities for growth in the Biomaterial Market. Examples of these products include hydrogen scaffolding and decellularized dermal matrixes for grafting.
The Role of Polymers in Market Revenue for Biomaterials:
The polymer sector dominated the global Biomaterial Market revenue in 2023 and is expected to maintain its dominance. This is attributable mainly to the variety of uses for polymer goods. The segment’s revenue growth is anticipated to accelerate due to the wide availability of biopolymers and the demand for advanced polymers for use in bio-resorbable tissue fixation applications and other orthopedic applications.
Regional Outlook:
The biomaterials industry has a bright future in this region, and various trends define it. The superior healthcare infrastructure and substantial research and development operations in North America biodegradable Biomaterial Market continue to make it a prominent competitor. Europe keeps pace, emphasizing novel applications and sustainable biomaterials. A growing medical biomaterials industry, aging populations, and rising healthcare spending all point to Asia Pacific having tremendous development potential.
Regional differences reflect various healthcare demands, regulatory frameworks, and economic dynamics. The global biomaterials industry is on a stable growth track. As biomaterials become more prevalent in medical and non-medical applications, collaboration between government, industry, and academic institutions may continue to change the regional landscape.
“Increasing consumer awareness of the advantages of products based on biomaterials and increased government funding for biomaterials research and development are contributing to the market expansion.” opines Sabyasachi Ghosh Associate Vice President at Future Market Insights (FMI) analyst.
Our Analyst Is Here To Assist You With Any Questions Get In Touch Now! https://www.futuremarketinsights.com/ask-question/rep-gb-15168
Key Takeaways:
- The polymer biomaterials segment of the material type category to grab a share of 33.5% by 2033.
- In the end-user category, the cardiology segment accounts for a market share of 21.1% during the forecast period.
- By 2033, the United States market is expected to possess a 23.2% share.
- The North America market is forecast to have a 28.5% market share by 2033.
- By 2033, Germany is expected to hold 4.7% of the market share.
- Until 2033, the China may grab a share of 8.3%.
- The India market is going to continue to hold a share of 8% through 2033.
- Until 2033, the market in the United Kingdom is anticipated to grab a share of 4%.
- The United States market to exhibit a CAGR of 6% from 2023 to 2033.
- The United Kingdom market to register a CAGR of 5.5% between 2023 and 2033.
- Germany market to develop at a CAGR of 6.1% between 2023 and 2033.
- China market to record a CAGR of 13.3% through 2033.
- India market is to exhibit a CAGR of 15% from 2023 to 2033.
Biomaterial Market Size:
| Attributes | Details |
| Biomaterials Industry Value for 2023 | US$ 1,72,689.3 million |
| Biomaterials Industry Value for 2033 | US$ 3,86,983.6 million |
| Biomaterials Industry CAGR from 2023 to 2033 | 8.4% |
Competitive Analysis:
Important biomaterials manufacturers invest heavily to grow their presence and keep a competitive edge. They are also implementing techniques to improve their product catalog, including contracts, collaborations, and collaborative models. Significant biomaterials manufacturers are prone to creating more inventive items to increase their selection of biomaterials.
Recent Breakthroughs:
- To create bioprinted tissue treatments for obesity and diabetes, Novo Nordisk partnered with Aspect Biosystems, a business that produces bioprinted biomaterials, in April 2023.
- After the Huafon Group purchased DuPont Biomaterials, Covation Biomaterials, a global provider of bio-based solutions, was born as a separate company in June 2022.
- DuPont and JP Modatex India debuted a new spun yarn collection in April 2022 that combines natural fibers with DuPont Sorona staple fibers. The group makes spun yarns appropriate for various uses, including dresses, shirting, pants and skirts, jeans, and jackets, by combining linen and partially plant-based Sorona fibers.
Discover the Future of Marketing: Get Your Hands on Our Customization Report! https://www.futuremarketinsights.com/customization-available/rep-gb-15168
Key Biomaterials Manufacturers:
- BASF SE
- Evonik Industries AG
- Royal DSM N.V.
- Corbion N.V.
- Covestro AG
- Zimmer Biomet Holdings, Inc.
- Stryker Corporation
- Medtronic plc
- DENTSPLY SIRONA Inc.
- Wright Medical Group N.V.
- Baxter International Inc.
- Integra LifeSciences Holdings Corporation
- Johnson & Johnson
- Carpenter Technology Corporation
- Invibio Ltd.
- CAM Bioceramics B.V.
- Biomatlante
- Biomet, Inc.
- Aap Implantate AG
- Orthofix Medical Inc.
Key Segments:
By Material Type:
- Ceramic Biomaterials
- Surface Reactive/Bioactive
- Non-Absorbable
- Polymer Biomaterials
- Metallic Biomaterials
- Natural Materials
- Other Materials
By Application:
- Cardiology
- Ophthamology
- Dental
- Neurology
- Orthopaedic
- Respiratory
- Wound Management
- Aesthetic & Plastic Surgery
- Tissue Engineering & Regenerative Medicine
- Other Applications
By End Users:
- Pharmaceuticals/Biotech Manufacturers
- Medical Device Manufacturers
- Cosmetic & Aesthetic Products Manufacturers
- Tissue Engineering and Regenerative Medicine Companies
- Research Laboratories
- Acaedmic Institutions
By Region:
- North America
- Latin America
- East Asia
- South Asia Pacific
- Western Europe
- Eastern Europe
- The Middle East & Africa
Get The Insights You Need To Succeed In The Biomaterials Market With Our Discounted Intelligence Report: https://www.futuremarketinsights.com/checkout/15168
About Future Market Insights (FMI)
Future Market Insights, Inc. (ESOMAR certified, recipient of the Stevie Award, and a member of the Greater New York Chamber of Commerce) offers profound insights into the driving factors that are boosting demand in the market. FMI stands as the leading global provider of market intelligence, advisory services, consulting, and events for the Packaging, Food and Beverage, Consumer Technology, Healthcare, Industrial, and Chemicals markets. With a vast team of over 5000 analysts worldwide, FMI provides global, regional, and local expertise on diverse domains and industry trends across more than 110 countries.
Contact Us:
Future Market Insights Inc.
Christiana Corporate, 200 Continental Drive,
Suite 401, Newark, Delaware – 19713, USA
T: +1-845-579-5705
For Sales Enquiries: sales@futuremarketinsights.com
Website: https://www.futuremarketinsights.com
LinkedIn| Twitter| Blogs | YouTube